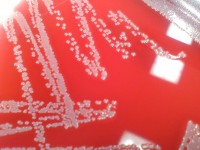
cung doi pho con dai dich khang thuoc khang sinh

| TIN LIÊN QUAN | |
| 7 loại thực phẩm bạn nên dự trữ vào mùa lạnh | |
| Thế giới cam kết đối phó với tình trạng kháng kháng sinh | |
Ngày 21/9 vừa qua, phiên họp lần thứ 71 của Đại hội đồng Liên hợp quốc (LHQ) đã diễn ra tại New York, Mỹ. Lãnh đạo từ 193 quốc gia thành viên đã tụ họp để giải quyết các vấn đề cấp bách, trong đó báo động mức độ nghiêm trọng chưa từng có của việc lây lan các bệnh lý nhiễm trùng có khả năng kháng thuốc kháng sinh.
Đây là lần thứ tư trong lịch sử LHQ có một vấn đề sức khỏe được thảo luận tại Đại hội đồng, sau các cuộc thảo luận về HIV, bệnh không truyền nhiễm và Ebola. Tại đây, các đại biểu đã nhấn mạnh vai trò và trách nhiệm quan trọng của chính phủ, cũng như các tổ chức liên chính phủ có liên quan, đặc biệt là Tổ chức Y tế Thế giới (WHO).
 |
Tại kỳ họp này, Tổng thư ký LHQ Ban Ki-moon nêu những con số ám ảnh khi hơn 200.000 trẻ sơ sinh tử vong mỗi năm do hậu quả của nhiễm trùng không đáp ứng với những loại kháng sinh có sẵn; là dịch thương hàn đa kháng thuốc đang càn quét tại châu Phi; là tình trạng kháng điều trị HIV/AIDS đang gia tăng hay vi khuẩn lao kháng thuốc tại 105 quốc gia…
Kháng sinh được sử dụng để điều trị các bệnh có nguyên nhân do nhiễm khuẩn. Tuy nhiên, nếu sử dụng không đúng cách hoặc lạm dụng sẽ gây ra tình trạng kháng kháng sinh, có nghĩa vi khuẩn không bị tiêu diệt mà sẽ sinh sôi nảy nở và gây nguy hiểm cho tính mạng người bệnh.
Có hai nguyên nhân phổ biến, đó là sử dụng kháng sinh không theo chỉ dẫn của bác sỹ và lạm dụng thuốc kháng sinh. Điều này dẫn tới hệ quả là kháng sinh không diệt được vi khuẩn gây bệnh mà còn vô tình giúp cho vi khuẩn đó thích nghi, biến đổi để không còn bị kháng sinh đó tiêu diệt. Đây là hai nguyên nhân thường gặp ở Việt Nam.
Các cơ sở khám chữa bệnh tuyến trên thường bị quá tải do người bệnh được đưa đến thường trong tình trạng nguy hiểm vì trước đó đã dùng nhiều loại kháng sinh nhưng không đỡ. Khi đó, bác sỹ phải dùng thuốc kháng sinh rất đắt tiền, phối hợp nhiều loại kháng sinh hoặc phải làm kháng sinh đồ để tìm xem còn loại kháng sinh nào mà vi khuẩn đó có thể bị tiêu diệt. Việc làm kháng sinh đồ cần nhiều thời gian, gây tổn thất lớn cho người bệnh.
Đó cũng là vấn nạn chung của toàn thế giới, nhất là khi việc tìm ra các loại kháng sinh mới không theo kịp với tình trạng kháng kháng sinh. Khi đã nhiễm khuẩn ở các cơ quan quan trọng như não, tim, phổi, gan, thận… người bệnh đối mặt với nguy cơ tử vong rất cao. Do vậy, có thể nói, tình trạng kháng thuốc kháng sinh đang đe dọa sự tồn vong của cả loài người.
Hơn lúc nào hết, trong khi chờ đợi các nhà khoa học tìm ra siêu kháng sinh thì người dân cần chủ động, tự giác tuân thủ phương pháp điều trị mà thầy thuốc lựa chọn, không lạm dụng sử dụng kháng sinh. Sự tự giác này của từng cá nhân không những giúp bảo vệ mạng sống của chính bản thân mình mà còn bảo vệ sức khỏe bền vững của cả cộng đồng.
Ở tầm vĩ mô, một Bộ hay một quốc gia không thể tự giải quyết vấn đề này mà không có sự chung tay của tất cả các Bộ, ngành hữu quan, bên cạnh đó là sự phối hợp giữa các quốc gia và công ty dược phẩm đa quốc gia trên thế giới. Để giải quyết thách thức đối với sức khỏe, an ninh lương thực và duy trì phát triển toàn cầu cần tới một nỗ lực tập thể như các nước thành viên LHQ đã tái cam kết tại kỳ họp Đại hội đồng lần thứ 71 vừa qua.
 | Tôm Ấn Độ bị Mỹ từ chối nhập do sử dụng nhiều kháng sinh Trong 7 tháng đầu năm 2016, tôm Ấn Độ đã chiếm 75% trong số lô hàng bị từ chối nhập khẩu vào Mỹ do nhiễm ... |
| Phát hiện chất kháng sinh cực mạnh trong... mũi người Một nhóm nhà nghiên cứu Đức mới đây đã tìm thấy một vi khuẩn hữu ích, có khả năng sản sinh chất kháng sinh cực ... |
 | Mỹ: Thêm bệnh nhân nhiễm siêu vi khuẩn Ngày 27/6, giới chức khoa học Mỹ thông báo đã ghi nhận trường hợp thứ 2 mắc siêu vi khuẩn kháng tất cả mọi loại ... |



































